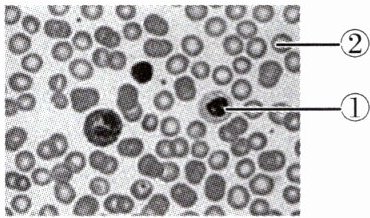

第40页
- 第1页
- 第2页
- 第3页
- 第4页
- 第5页
- 第6页
- 第7页
- 第8页
- 第9页
- 第10页
- 第11页
- 第12页
- 第13页
- 第14页
- 第15页
- 第16页
- 第17页
- 第18页
- 第19页
- 第20页
- 第21页
- 第22页
- 第23页
- 第24页
- 第25页
- 第26页
- 第27页
- 第28页
- 第29页
- 第30页
- 第31页
- 第32页
- 第33页
- 第34页
- 第35页
- 第36页
- 第37页
- 第38页
- 第39页
- 第40页
- 第41页
- 第42页
- 第43页
- 第44页
- 第45页
- 第46页
- 第47页
- 第48页
- 第49页
- 第50页
- 第51页
- 第52页
- 第53页
- 第54页
- 第55页
- 第56页
- 第57页
- 第58页
- 第59页
- 第60页
- 第61页
- 第62页
- 第63页
- 第64页
- 第65页
- 第66页
- 第67页
- 第68页
- 第69页
- 第70页
- 第71页
- 第72页
- 第73页
- 第74页
- 第75页
- 第76页
- 第77页
- 第78页
- 第79页
- 第80页
- 第81页
- 第82页
- 第83页
- 第84页
- 第85页
- 第86页
- 第87页
- 第88页
- 第89页
- 第90页
- 第91页
- 第92页
- 第93页
- 第94页
- 第95页
- 第96页
- 第97页
- 第98页
- 第99页
- 第100页
- 第101页
- 第102页
- 第103页
- 第104页
- 第105页
- 第106页
- 第107页
- 第108页
- 第109页
- 第110页
- 第111页
- 第112页
- 第113页
- 第114页
- 第115页
- 第116页
- 第117页
- 第118页
- 第119页
- 第120页
- 第121页
- 第122页
- 第123页
- 第124页
- 第125页
- 第126页
- 第127页
- 第128页
- 第129页
- 第130页
- 第131页
- 第132页
- 第133页
- 第134页
- 第135页
- 第136页
- 第137页
- 第138页
- 第139页
- 第140页
- 第141页
- 第142页
- 第143页
- 第144页
- 第145页
- 第146页
- 第147页
- 第148页
- 第149页
- 第150页
- 第151页
- 第152页
- 第153页
- 第154页
- 第155页
- 第156页
10. 人体血液的组成是(
A.血浆与白细胞
B.血浆与血细胞
C.血小板与血浆
D.红细胞与血浆
B
)A.血浆与白细胞
B.血浆与血细胞
C.血小板与血浆
D.红细胞与血浆
答案:
10.B
11. 下表是人体内四种组织处血红蛋白与氧气的结合情况。四种组织中呼吸作用最旺盛的是(

A.Ⅰ
B.Ⅱ
C.Ⅲ
D.Ⅳ
D
)
A.Ⅰ
B.Ⅱ
C.Ⅲ
D.Ⅳ
答案:
11.D
12. 科学家研发了一种促凝剂纳米颗粒,在实验中有助于出血动物的血液更快地形成凝块并止血。促凝剂纳米颗粒的功能相当于(
A.红细胞
B.血浆
C.白细胞
D.血小板
D
)A.红细胞
B.血浆
C.白细胞
D.血小板
答案:
12.D
13. 妈妈切菜时不小心切伤了手,伤口很快止血。在此过程中起作用的是(
A.血糖
B.血小板
C.红细胞
D.白细胞
B
)A.血糖
B.血小板
C.红细胞
D.白细胞
答案:
13.B
14. 当儿童的扁桃体发炎时,血液里数量明显增多,并能吞噬病菌的是(
A.红细胞
B.血小板
C.血浆
D.白细胞
D
)A.红细胞
B.血小板
C.血浆
D.白细胞
答案:
14.D
15. 将人血永久涂片放在显微镜下观察,视野如图所示,下列有关说法正确的是(

A.当人体有炎症时,①的数量会明显增多
B.江苏志愿者到西藏支教半年后,血液中的②显著增加
C.③具有止血、凝血的功能
D.④中含量最多的物质是血红蛋白
C
)
A.当人体有炎症时,①的数量会明显增多
B.江苏志愿者到西藏支教半年后,血液中的②显著增加
C.③具有止血、凝血的功能
D.④中含量最多的物质是血红蛋白
答案:
15.C
16. 血栓是指心脏、血管内的血液发生凝固或血液中存在凝集所形成的固体质块。研究人员称大蒜能有效减少血栓形成,你认为最可能的原因是大蒜能(
A.提高血浆的运输能力
B.抑制白细胞吞噬细菌
C.促进红细胞运输氧
D.抑制血小板不正常凝集
D
)A.提高血浆的运输能力
B.抑制白细胞吞噬细菌
C.促进红细胞运输氧
D.抑制血小板不正常凝集
答案:
16.D
17. 如图为光学显微镜下的血液涂片,下列相关叙述正确的是(

A.血液是由①②和血小板构成的
B.①有吞噬侵入人体的病菌的作用
C.②有促进止血的作用
D.血小板能够运输氧气和二氧化碳
B
)
A.血液是由①②和血小板构成的
B.①有吞噬侵入人体的病菌的作用
C.②有促进止血的作用
D.血小板能够运输氧气和二氧化碳
答案:
17.B
18. 如图是人体血液和血细胞的组成图,下列有关说法错误的是(

A.④是淡黄色、半透明的液体,主要成分是水
B.血液中具有运输功能的是③和④
C.血细胞中能穿过毛细血管壁、具有吞噬作用的是①
D.③的结构呈两面凹的圆饼状,主要运输二氧化碳
D
)
A.④是淡黄色、半透明的液体,主要成分是水
B.血液中具有运输功能的是③和④
C.血细胞中能穿过毛细血管壁、具有吞噬作用的是①
D.③的结构呈两面凹的圆饼状,主要运输二氧化碳
答案:
18.D
19. 某人就医时,医生根据验血结果判断其身体发生急性炎症,其判断依据可能是(
A.红细胞数量减少
B.血小板数量增多
C.白细胞数量增多
D.血红蛋白数量减少
C
)A.红细胞数量减少
B.血小板数量增多
C.白细胞数量增多
D.血红蛋白数量减少
答案:
19.C
查看更多完整答案,请扫码查看


